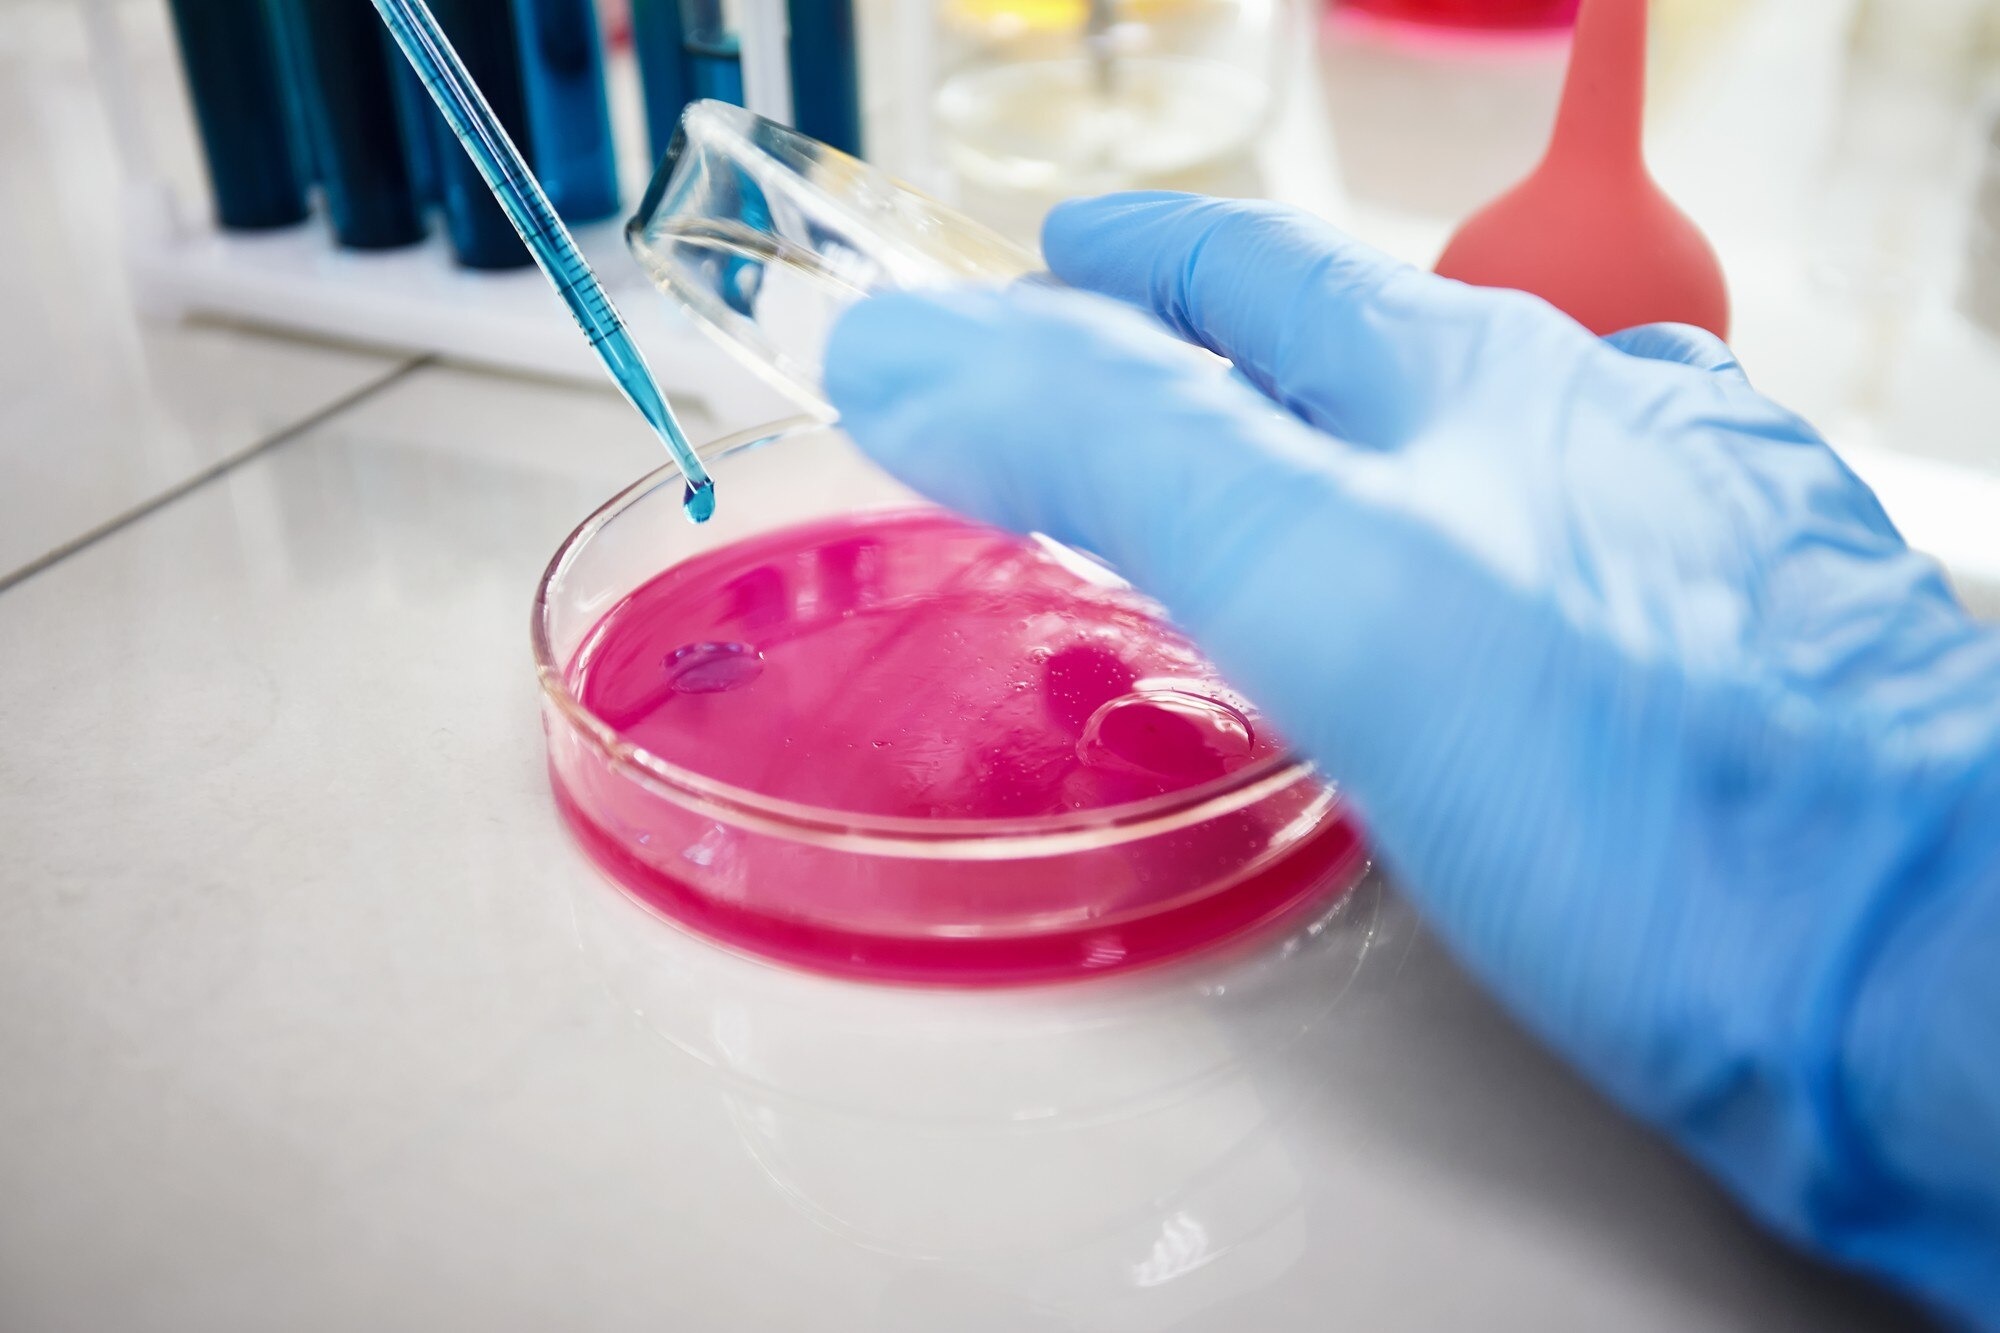
Protein A Chromatography Resin

As you move from bench-scale antibody development to commercial biologics manufacturing, your purification strategy becomes one of the most critical determinants of yield, cost, and regulatory success. Scaling up biologics production is not just about increasing bioreactor volume. It requires robust downstream processes that maintain purity, activity, and consistency across batches.
One of the most trusted tools in this process is Protein A Chromatography Resin. When you implement the right resin and optimize your workflow, you can significantly improve antibody recovery, reduce impurities, and streamline large-scale purification.
In this article, you will learn how to scale up biologics production using Protein A chromatography effectively, avoid common pitfalls, and ensure reliable performance at industrial volumes.
Why Protein A Remains the Gold Standard for Antibody Purification
If you are producing monoclonal antibodies (mAbs) or Fc-fusion proteins, Protein A affinity chromatography is likely already part of your workflow. Protein A selectively binds to the Fc region of IgG antibodies, allowing you to capture your target molecule with high specificity in a single step.
At scale, this selectivity becomes even more valuable. Instead of relying on multiple polishing steps to remove host cell proteins and impurities, you can achieve high purity immediately after capture. This reduces processing time and operational costs.
However, not all resins perform equally under industrial conditions. That is why selecting a high-performance Protein A Chromatography Resin for large-scale monoclonal antibody purification is critical for success.
You can explore advanced solutions for industrial applications through this high-capacity Protein A Chromatography Resin for scalable antibody purification processes.
Understanding the Challenges of Scale-Up
When you scale up biologics production, you face several technical challenges:
- Increased column diameter and bed height
- Higher flow rates
- Pressure limitations
- Resin lifetime and cleaning cycles
- Batch-to-batch consistency
At laboratory scale, minor inefficiencies may go unnoticed. But at commercial scale, even a small drop in binding capacity can translate into significant product loss.
To overcome these challenges, you must focus on:
- Resin mechanical stability
- Dynamic binding capacity (DBC) at high flow rates
- Chemical stability during repeated cleaning-in-place (CIP) cycles
- Low ligand leaching
Choosing a robust resin from a trusted supplier such as Lytic Solutions, LLC ensures that your downstream process remains stable during scale expansion. Learn more about scalable purification technologies from Lytic Solutions, LLC.
Step-by-Step Strategy to Scale Using Protein A Resin
Start with Process Characterization
Before scaling, thoroughly characterize your process at pilot scale. Evaluate:
- Binding capacity at various residence times
- Pressure-flow behavior
- Elution profile consistency
- Cleaning efficiency
You should determine the optimal residence time that balances productivity and binding performance. Shorter residence times increase throughput but may reduce capacity if not optimized.
Maintain Linear Scale-Up Principles
When moving from pilot to manufacturing scale, maintain:
- Same bed height
- Same linear flow velocity
- Same residence time
Scaling by increasing column diameter rather than bed height helps preserve separation efficiency. This ensures your antibody recovery and purity remain consistent across volumes.
Optimize Load Density
Loading too aggressively can reduce binding efficiency and increase aggregate formation. Instead of simply maximizing volume, calculate load density based on dynamic binding capacity at your chosen flow rate.
Running at 70–80% of DBC often provides a good balance between productivity and resin longevity.
Implement Effective Cleaning-in-Place (CIP)
At large scale, resin reuse directly impacts cost per gram of antibody. Effective CIP protocols prevent fouling and maintain performance over dozens or even hundreds of cycles.
You should validate:
- NaOH tolerance
- Ligand stability
- Minimal protein carryover
A chemically stable Protein A Chromatography Resin ensures consistent performance under repeated sanitization conditions.
Monitor Resin Lifetime
Track:
- Binding capacity decline
- Pressure increase
- Impurity breakthrough
Data-driven monitoring allows you to replace resin before performance drops below acceptable thresholds. This protects both yield and regulatory compliance.
Benefits of Using High-Quality Protein A Chromatography Resin
When you select a premium resin for large-scale biologics manufacturing, you gain:
- High dynamic binding capacity
- Faster processing times
- Lower ligand leakage
- Strong alkaline stability
- Extended resin lifetime
These factors directly reduce cost of goods (COGs) while maintaining product quality.
In commercial antibody production, even a 5% improvement in yield can translate into substantial financial impact. By investing in the right Protein A Chromatography Resin, you secure both technical reliability and economic efficiency.
Regulatory Considerations in Large-Scale Production
As you scale, regulatory scrutiny increases. Authorities expect:
- Resin traceability
- Validation of cleaning procedures
- Leachables and extractables analysis
- Reproducible batch records
Using a well-documented resin platform simplifies regulatory submissions. It also reduces risk during process validation and technology transfer.
You should document:
- Resin lot numbers
- Cycle history
- Cleaning conditions
- Performance trends
Proactive documentation ensures smooth audits and faster approval timelines.
Future-Proofing Your Biologics Platform
Biologics pipelines continue to expand. You may develop new monoclonal antibodies, bispecific antibodies, or Fc-fusion proteins in the future. Choosing a versatile Protein A Chromatography Resin today allows you to adapt without redesigning your downstream process.
Look for resins that support:
- High-throughput manufacturing
- Continuous processing compatibility
- High-concentration feed streams
- Advanced process analytical technologies (PAT)
By aligning your purification strategy with scalable, high-performance resin systems, you create a foundation for long-term manufacturing success.
Final Thoughts
When you scale up biologics production, your purification strategy determines efficiency, profitability, and compliance. Protein A Chromatography Resin remains the industry standard for antibody capture because of its selectivity, reliability, and scalability.
By carefully optimizing load conditions, maintaining linear scale-up parameters, validating cleaning cycles, and monitoring resin performance, you can achieve consistent high-yield antibody production at commercial scale.
If you are preparing to transition from pilot to manufacturing volumes, now is the time to evaluate whether your current resin platform can support long-term growth.
Frequently Asked Questions
Why is Protein A Chromatography Resin widely used in biologics production?
Protein A Chromatography Resin selectively binds to the Fc region of IgG antibodies, allowing high-purity capture in a single step. This reduces processing time and simplifies downstream workflows.
How do you scale up Protein A chromatography effectively?
You scale up by maintaining bed height, residence time, and linear flow velocity while increasing column diameter. Proper load optimization and validation are essential.
How many cycles can Protein A Chromatography Resin withstand?
High-quality resins can tolerate dozens to hundreds of cleaning cycles, depending on process conditions and NaOH stability.
What factors affect resin lifetime?
Resin lifetime depends on cleaning protocols, feedstock impurity levels, operating pressure, and chemical stability.
How does resin selection impact manufacturing costs?
Resins with higher binding capacity and longer lifetime reduce cost per gram of antibody, improve productivity, and minimize downtime.
Scaling biologics production requires strategic planning and the right purification tools. With a reliable Protein A Chromatography Resin platform and expert support from Lytic Solutions, LLC, you can build a purification process that performs consistently from pilot scale to full commercial manufacturing.